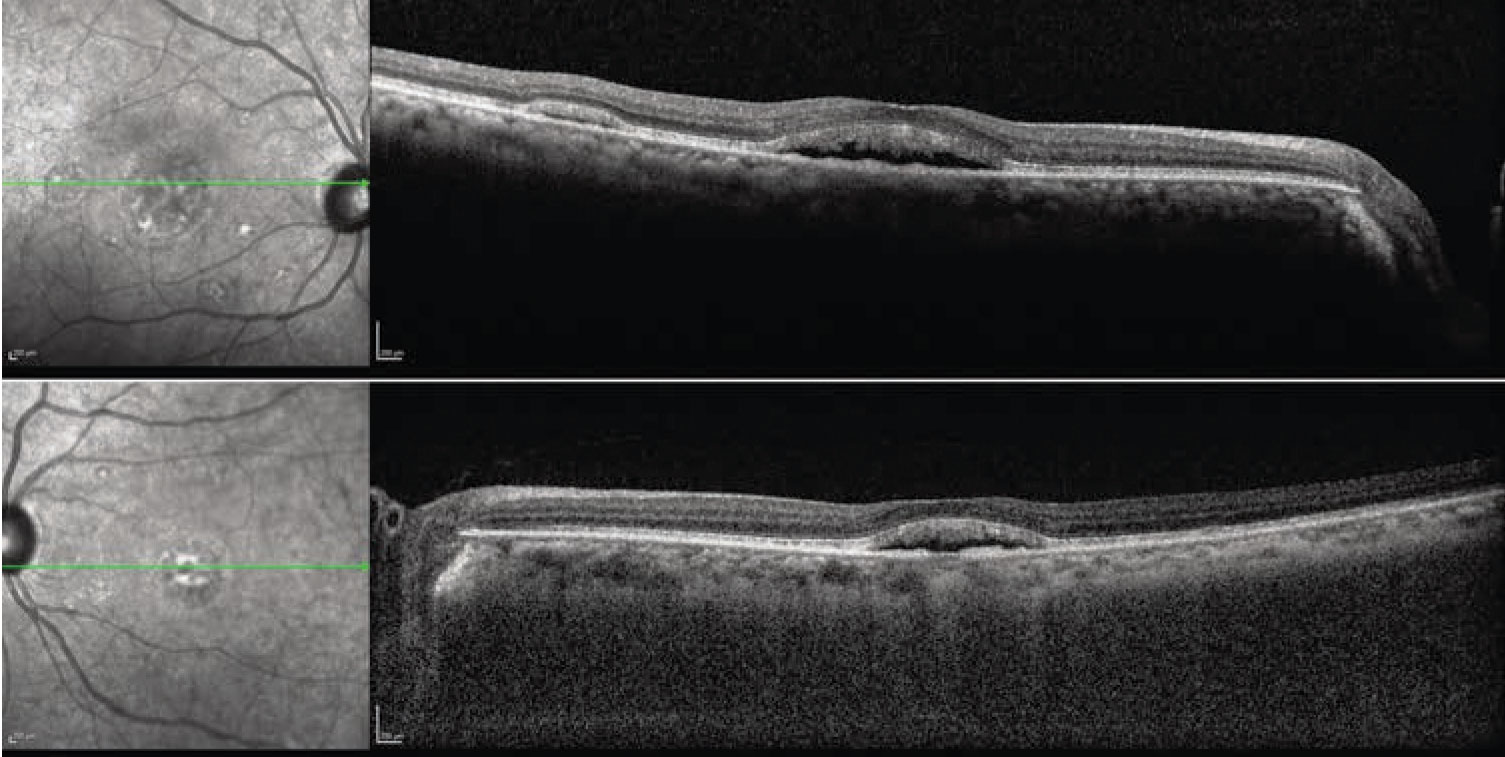

|
|
Bios
Dr. Hinkle is a first-year vitretoretinal fellow at Wills Eye Hospital/ Dr. Hsu is with Mid Atlantic Retina/Retina Service, Wills Eye Hospital. DISCLOSURES: Drs. Hinkle and Hsu have no relevant financial relationships to disclose. |
A 69-year-old man was referred to the retina clinic for evaluation of blurred vision in both eyes over the preceding several weeks. His medical history included Erdheim-Chester disease, hypertension, and gastroesophageal reflux disease, but his ocular history was unremarkable.
 |
Work-up and imaging findings
At presentation, the patient’s visual acuity was 20/40 OD and 20/70 OS, and intraocular pressures were within normal limits bilaterally. His anterior segment exam showed 1+ nuclear sclerosis in both eyes. No cell or flare was noted.
The fundus examination was remarkable for bilateral, multifocal areas of subretinal fluid (SRF) in the macula, including foveal involvement. There were no abnormalities in the periphery (Figure 1). Optical coherence tomography scans demonstrated subfoveal fluid in both eyes with multifocal, smaller collections of SRF. The interdigitation zone was thickened and irregular. With enhanced-depth imaging, the choroid appeared to be not substantially thickened bilaterally (Figure 2).
Given the ophthalmoscopic exam, we pursued further diagnostic imaging. Fundus autofluorescence revealed bilateral areas of hyperautofluorescence that correlated to the accumulation of SRF. We observed no foci of hyperautofluorescence in the periphery. Absent were gravity-dependent fluid shifts, or guttering (Figure 3).
Fluorescein angiography demonstrated a normal vascular pattern in both eyes. There was no evidence of dye leakage from the microvasculature or leakage into the collections of subretinal fluid (Figure 4).
 |
|
Figure 1. Fundus examination shows multifocal areas of subretinal fluid bilaterally. |
Additional history and diagnosis
The patient’s Erdheim-Chester disease (ECD) had been resistant to multiple therapies. However, before the onset of visual symptoms, he had started treatment with the BRAF enzyme inhibitor vemurafenib (marketed as Zelboraf), followed by the MEK inhibitor cobimetinib. (MEK stands for MAPK/ERK kinase, or mitogen-activated protein kinases [MAPKs], including extracellular signal-regulated kinases [ERKs].)
After he started the cobimetinib, the patient noticed changes in his vision. Given this history and the constellation of imaging findings, we diagnosed MEK inhibitor-associated retinopathy (MEKAR).
|
|
Figure 2. Optical coherence tomography scans demonstrate subfoveal and extrafoveal subretinal fluid. |
Follow-up
Although we counseled the patient that there was no definitive ocular indication to stop the MEK inhibitor, he was very bothered by the visual changes. After consulting with his oncologist, he decided to discontinue the cobimetinib. Four weeks after the initial visit, his visual acuity had improved to 20/40 OU.
A fundus examination showed a stable number of subretinal foci compared to the first visit. OCT scans showed interval improvement in the amount of SRF (Figure 5, page 12). OCT angiography didn’t show any evidence of macular neovascularization (Figure 6, page 13). The SRF was nearly resolved at the four-month follow-up, and visual acuity had improved to 20/30 OD and 20/40 OS, although subfoveal changes persisted (Figure 5).
 |
|
Figure 3. Fundus autofluorescence shows hyperautofluorescence corresponding to areas of subretinal fluid. |
Novel treatments, novel side effects
After clinical trials reported that trametinib increased patient survival, this MEK inhibitor was the first medication of its class approved to treat metastatic melanoma in 2013.1 The RAS-RAF-MEK-ERK signaling pathway leads to cell cycle progression, and dysregulation of this cascade sequence is widely implicated in malignant cell proliferation. Within this sequence, MEKs phosphorylate and activate MAPK/ERK.2 By blocking downstream effects, MEK inhibitors block tumor growth and induce cell death via apoptosis.2
 |
In addition to melanoma, MEK inhibitors have been used in a growing range of oncologic conditions, including ovarian cancer, leukemia, lymphoma, thyroid cancer, colorectal cancer, non-small cell lung cancer, biliary cancer and pancreatic cancer.3 Our patient was treated with cobimetinib, another MEK inhibitor approved by the Food and Drug Administration to treat advanced melanoma. ECD is a rare systemic histiocytic neoplasm that can involve almost any organ system, although it manifests most frequently in the bone.4 Constitutive MAPK signaling has been shown to drive ECD, and growing evidence supports the efficacy of MEK inhibitors in this condition.5
A range of ocular adverse events are associated with MEK inhibitors, particularly blurred vision and characteristic subretinal fluid accumulation. This drug class-related effect has been termed MEK inhibitor associated retinopathy (MEKAR). It was first recognized as a “central serous chorioretinopathy-like” adverse event in oncology clinical trials, but has since been noted to be a distinct entity.6 BRAF inhibitors are often used in combination with MEK inhibitors to increase efficacy. These molecules are associated with uveitis but not with retinal changes.7 However, the combination of MEK inhibitors and BRAF inhibitors may lead to more ocular toxicities.8,9
 |
| Figure 4. Fluorescein angiography doesn’t show any abnormal dye leakage or pooling |
Clinical characteristics of MEKAR
The understanding of MEKAR has evolved from case reports and case series.10-12 SRF has been noted on examination in up to 90 percent of patients undergoing treatment with a MEK inhibitor. When it occurs, it’s bilateral in more than 90 percent of cases.13,14 Intensive monitoring of some clinical trial patients have shown rapid accumulation of SRF (within three hours of administration of the MEK inhibitor) followed by even more rapid resolution (by the fourth hour), although a large portion of patients continue to have SRF at their final follow-up visit.13 As this patient demonstrated, in spite of the SRF, fluorescein angiography doesn’t demonstrate pooling or leakage in
MEKAR.
 |
| Figure 5. Optical coherence tomography scans at presentation (A, B), four weeks later (C, D) and four months later (E, F) demonstrate gradual resolution of subretinal fluid. |
Visual symptoms are much less common than the presence of SRF. In a larger series of patients, only 20 percent of those with SRF were symptomatic, typically reporting blurred vision.13
MEKAR has been termed CSR-like, but there are important differences between these two conditions. MEKAR is bilateral more than 90 percent of the time, while CSR is bilateral in less than half.14 MEKAR is also frequently multifocal, involves the posterior pole at the fovea and along the arcades, and has no gravitational effect on the fluid as is seen in CSR.14 Furthermore, the pigment epithelial detachments and increased choroidal thickness commonly observed in CSR don’t necessarily occur in MEKAR.14
 |
| Figure 6. Optical coherence tomography angiography four weeks after presentation shows no evidence of macular neovascularization (OD right column, OS left column). A and B show the superficial vascular complex, C and D the avascular complex. |
Treatment
The visual impacts of MEKAR are typically mild. As we note, many patients with SRF are asymptomatic, and those who have symptoms don’t usually experience a decrease in vision of more than two lines.14 Subjective visual changes frequently resolve within one month even if SRF persists, and final visual acuity remains within one line of the pretreatment baseline.13 At the end of clinical trials, residual SRF after medication discontinuation was observed, but in less than 5 percent of cases.13 Given these characteristics, cessation of the MEK inhibitor is generally not indicated in the setting of ocular adverse events alone.13,14
Bottom line
As these lifesaving medications are used in an expanding number of conditions, MEKAR is an important, increasingly common etiology for SRF. Although the fluid is usually bilateral, subfoveal and multifocal, the visual impact is usually mild and self-limited. Management should be coordinated with a patient’s oncology team, and many patients can continue taking the medication safely. RS
REFERENCES
1. Flaherty KT, Robert C, Hersey P, et al; METRIC Study Group. Improved survival with MEK inhibition in BRAF-mutated melanoma. N Engl J Med. 2012;367:107-114.
2. Downward J. Targeting RAS signaling pathways in cancer therapy. Nat Rev Cancer. 2003;3:11–22.)
3. Duncan KE, Chang LY, Patronas M. MEK inhibitors: a new class of chemotherapeutic agents with ocular toxicity. Eye (Lond). 2015;29:1003-1012.
4. Goyal G, Heaney ML, Collin M, et al. Erdheim-Chester disease: consensus recommendations for evaluation, diagnosis, and treatment in the molecular era. Blood. 2020;135:1929-1945.
5. Diamond, EL, Durham, BH, Ulaner, GA, et al. Efficacy of MEK inhibition in patients with histiocytic neoplasms. Nature. 2019;567:521–524.
6. McCannel TA, Chmielowski B, Finn RS, et al. Bilateral subfoveal neurosensory retinal detachment associated with MEK inhibitor use for metastatic cancer. JAMA Ophthalmol. 2014;132:1005–1009.
7. Choe CH, McArthur GA, Caro I, et al. Ocular toxicity in BRAF mutant cutaneous melanoma patients treated with vemurafenib. Am J Ophthalmol. 2014;158:831-837.e2.
8. Stjepanovic N, Velazquez-Martin JP, Bedard PL. Ocular toxicities of MEK inhibitors and other targeted therapies. Ann Oncol. 2016;27:998-1005.
9. Menzies AM, Long GV. Dabrafenib and trametinib, alone and in combination for BRAF-mutant metastatic melanoma. Clin Cancer Res. 2014;20:2035-2043.
10. Velez-Montoya R, Olson J, Petrash M, et al. Acute onset central serous retinopathy with MEK inhibitor use for metastatic cancer. Invest Ophthalmol Vis Sci. 2011:Eeabstract 2153.
11.Urner-Bloch U, Urner M, Stieger P, et al. Transient MEK inhibitor-associated retinopathy in metastatic melanoma. Ann Oncol. 2014;25:1437-1441.
12. Schoenberger SD, Kim SJ. Bilateral multifocal central serous-like chorioretinopathy due to MEK inhibition for metastatic cutaneous melanoma. Case Rep Ophthalmol Med. 2013;2013:673796.
13. Weber ML, Liang MC, Flaherty KT, Heier JS. Subretinal fluid associated with MEK inhibitor use in the treatment of systemic cancer. JAMA Ophthalmol. 2016;134:855–862.
14. Francis JH, Habib LA, Abramson DH, et al. Clinical and morphologic characteristics of MEK inhibitor-associated retinopathy: differences from central serous chorioretinopathy. Ophthalmology. 2017;124:1788-1798.



